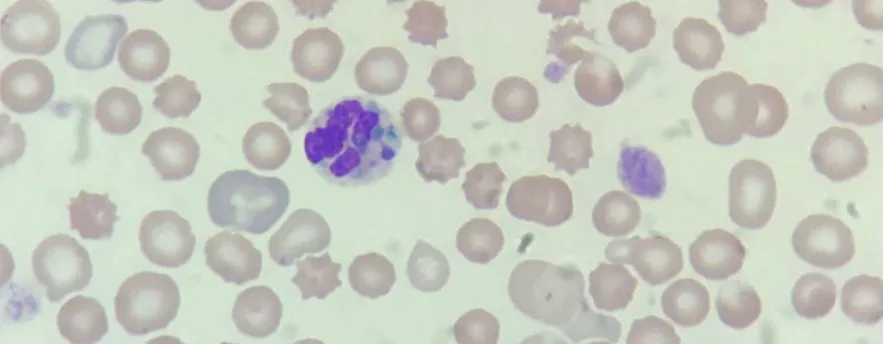

Cristais da Morte: Importância Clínica
O hemograma é um exame fundamental na rotina hospitalar, pois fornece informações valiosas sobre a saúde do paciente. Embora os métodos automatizados tenham simplificado sua realização, ainda assim é necessário realizar esfregaços sanguíneos para análise morfológica e obtenção de resultados precisos. Entre os achados mais raros e graves que podem ser observados nesses esfregaços, destacam-se os cristais da morte, também conhecidos como grânulos verdes em neutrófilos.
Descrição dos Cristais da Morte
Pesquisadores descreveram pela primeira vez os cristais da morte em 2009, como inclusões azul-esverdeadas brilhantes presentes no citoplasma de neutrófilos. Essas estruturas peculiares se formam devido ao desgaste das células do fígado, o que resulta na liberação de um pigmento chamado lipofuscina, rico em gordura, na corrente sanguínea. A partir disso, os neutrófilos e/ou monócitos fagocitam e armazenam esse pigmento em seu citoplasma, o que torna os cristais visíveis ao se realizar o esfregaço sanguíneo e a coloração da lâmina.
Imagem: cristais da morte azul-esverdeados
Relevância Clínica
A presença dos cristais da morte no sangue periférico está fortemente correlacionada a condições graves, como insuficiência hepática aguda e acidose lática. Além disso, estudos mostraram que esses achados estão associados a taxas elevadas de morbidade e mortalidade. Durante a pandemia de COVID-19, por exemplo, médicos também observaram os cristais verdes da morte em pacientes afetados pelo SARS-CoV, o que indicava um prognóstico mais desfavorável.

Linhas de Pesquisa Sobre os Cristais da Morte
Pesquisas científicas têm demonstrado a importância dos cristais da morte como marcadores prognósticos em pacientes hospitalizados. Por exemplo, um estudo publicado no PubMed Central revelou que indivíduos que apresentaram a presença desses cristais tiveram desfechos fatais em um período de 24 a 72 horas. Dessa forma, ressalta-se a necessidade de os profissionais de saúde identificarem e comunicarem esses achados nos laudos dos exames hematológicos realizados em ambientes laboratoriais.
Além disso, outro artigo publicado na revista Hematology, Transfusion and Cell Therapy enfatizou a importância clínica dos grânulos verdes em neutrófilos. O estudo destacou que a presença desses grânulos está associada a uma alta taxa de mortalidade em pacientes criticamente enfermos. Nesse contexto, a identificação precoce desses achados pode permitir uma intervenção rápida e adequada para melhorar o prognóstico desses pacientes.
Conclusão
Neutrófilos e monócitos podem conter cristais da morte — achados clínicos raros, mas graves — que médicos associam fortemente à morbidade e mortalidade em pacientes hospitalizados. Diante disso, sua presença indica a necessidade de atenção e cuidados médicos intensivos.
Nesse sentido, a identificação e comunicação desses achados nos exames hematológicos são essenciais para fornecer informações relevantes e auxiliar no planejamento adequado do tratamento. No entanto, mais pesquisas e estudos são necessários para entender completamente o significado clínico desses cristais e, consequentemente, desenvolver estratégias terapêuticas mais eficazes.
O próximo passo de todo analista que deseja ter mais segurança na bancada
Todo analista que busca se destacar e se tornar um profissional mais atualizado, capacitado e qualificado para o mercado de trabalho precisa considerar uma pós-graduação.
Um profissional com especialização é valorizado na área laboratorial; esse é um fato inegável.
Unimos o útil ao agradável ao desenvolver uma pós-graduação em Hematologia Laboratorial e Clínica.
Para aqueles que procuram a comodidade de uma pós-graduação 100% online e ao vivo, sem abrir mão da excelência no ensino, temos a solução ideal.
Nossa metodologia combina teoria e prática da rotina laboratorial, garantindo um aprendizado efetivo.
Contamos com um corpo docente altamente qualificado, com os melhores professores do Brasil, referências em suas áreas de atuação.
No Instituto Nacional de Medicina Laboratorial, temos apenas um objetivo: mais do que ensinar, vamos tornar VOCÊ uma referência.
Toque no botão abaixo e conheça a pós-graduação em Hematologia Laboratorial e Clínica.
QUERO CONHECER TODOS OS DETALHES DA PÓS-GRADUAÇÃO
Referências:
PubMed Central (PMC). (2019). “Article Title.” Journal Name, Volume(Issue), Page Range.
HTCT. (2020). ” GRÂNULOS VERDES EM NEUTRÓFILOS: QUAL O SIGNIFICADO CLÍNICO DA PRESENÇA DOS GRÂNULOS DA MORTE?.” Hematology, transfusion and cell therapy 42(S2), 433-434.
Soos MP, et al. Blue-green neutrophilic inclusion bodies in the critically ill patient. Clinical Case Reports. 2019 may;7(6):1249-1252. DOI:10.1002/ccr3.2196.



